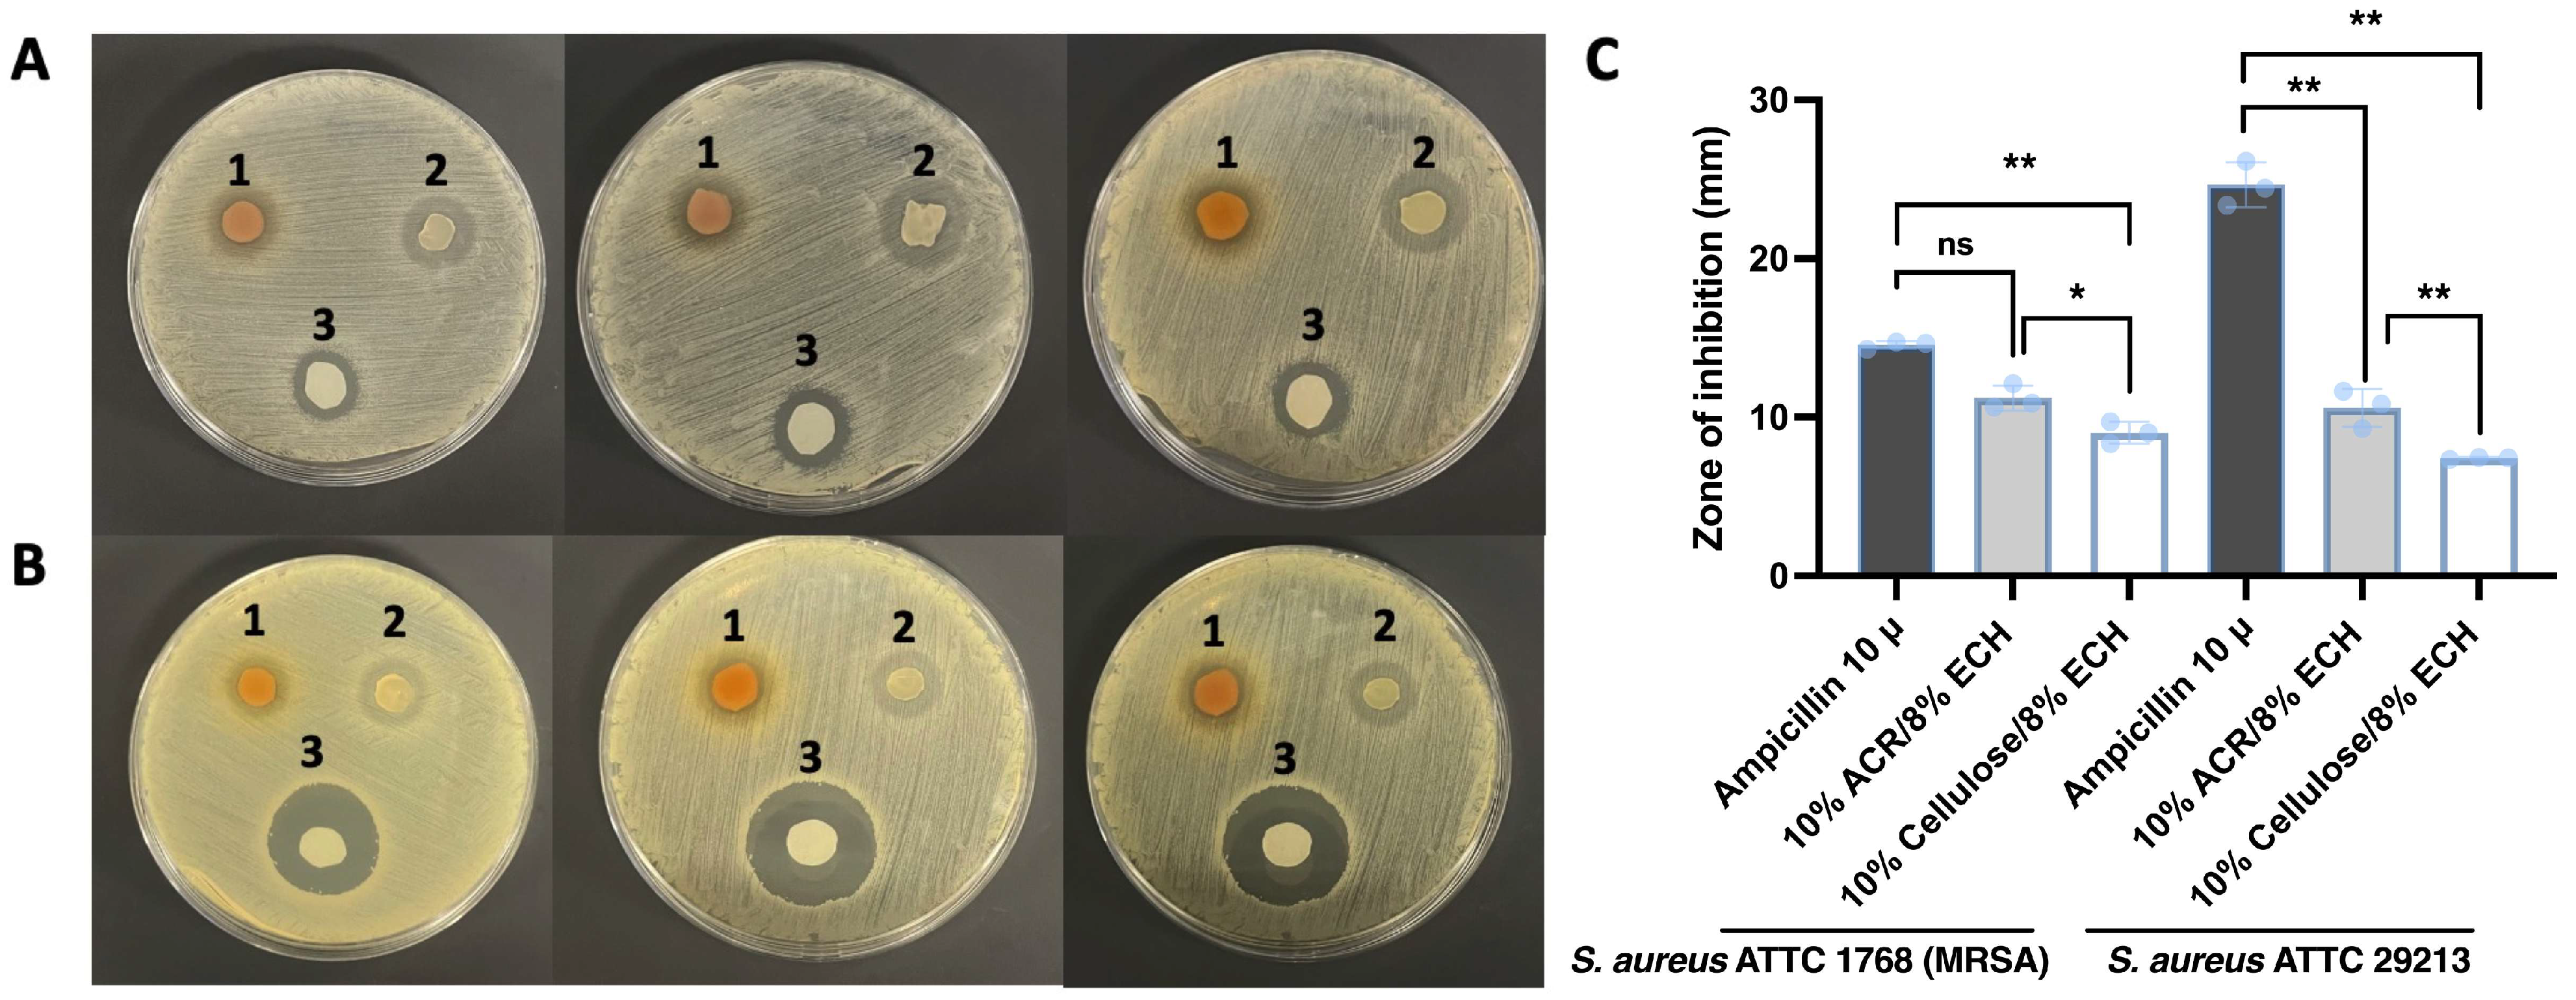
Ijms 26 04496 g005

Antrodia cinnamomea Residual Biomass-Based Hydrogel as a Novel UV-Protective and Antimicrobial Wound-Healing Dressing for Biomedical Use
Abstract
1. Introduction
2. Results and Discussion
2.1. UV-Protective Effects Mechanism of A. cinnamomea Residue Extracts on HaCaT Cells
2.2. Analysis of Sugar Composition and Bioactive Compounds in Residue
2.3. Swelling Property of Antrodia cinnamomea Residue Hydrogels
2.4. Morphological and Mechanical Properties of Antrodia cinnamomea Residue and Hydrogels
2.5. Strength, Stretchability, and Adhesion
2.6. Antimicrobial Activity of Hydrogels
3. Discussion
4. Materials and Methods
4.1. Materials and Chemicals
4.2. Preparation of A. cinnamomea Residual Biomass
4.3. Cellulose Extraction from A. cinnamomea Residual Biomass
4.4. Cell Culture and Treatment
4.5. Cytotoxicity Test by CCK8 Assay
4.6. Optimization Irradiation Factors
4.7. UVB Irradiation and Treatments
4.8. Determination of Cell Proliferation Activity
4.9. Western Blot
4.10. Quantitative HPLC Profiling of Residual Bioactive Metabolites in Antrodia cinnamomea Biomass
4.11. Analysis of Monosaccharide Profile in A. cinnamomea Biomass Residues by HPLC
4.12. Preparation of Hydrogels Using A. cinnamomea Residue and Residue-Derived Cellulose
4.13. Swelling Property of A. cinnamomea Residue Hydrogels
4.14. Morphology of Dried Residue Powder Derived from A. cinnamomea Residue and the Development of Seven Residue-Based Hydrogels
4.15. Tensile Properties of A. cinnamomea Residue Hydrogels
4.16. Cytotoxicity of Antrodia cinnamomea Residue Hydrogels
4.17. In Vitro Antimicrobial Potential of Hydrogels
Supplementary Materials
Author Contributions
Funding
Institutional Review Board Statement
Informed Consent Statement
Data Availability Statement
Conflicts of Interest
References
- Yang, H.-L.; Lin, K.-Y.; Juan, Y.-C.; Kumar, K.S.; Way, T.-D.; Shen, P.-C.; Chen, S.-C.; Hseu, Y.-C. The anti-cancer activity of Antrodia camphorata against human ovarian carcinoma (SKOV-3) cells via modulation of HER-2/neu signaling pathway. J. Ethnopharmacol. 2013, 148, 254–265. [Google Scholar] [CrossRef] [PubMed]
- Lu, M.-K.; Lin, T.-Y.; Chang, C.-C. Chemical identification of a sulfated glucan from Antrodia cinnamomea and its anti-cancer functions via inhibition of EGFR and mTOR activity. Carbohydr. Polym. 2018, 202, 536–544. [Google Scholar] [CrossRef] [PubMed]
- Chen, J.-J.; Lin, W.-J.; Liao, C.-H.; Shieh, P.-C. Anti-inflammatory benzenoids from Antrodia camphorata. J. Nat. Prod. 2007, 70, 989–992. [Google Scholar] [CrossRef] [PubMed]
- Kuo, M.-C.; Chang, C.-Y.; Cheng, T.-L.; Wu, M.-J. Immunomodulatory effect of Antrodia camphorata mycelia and culture filtrate. J. Ethnopharmacol. 2008, 120, 196–203. [Google Scholar] [CrossRef]
- Lee, I.-H.; Huang, R.-L.; Chen, C.-T.; Chen, H.-C.; Hsu, W.-C.; Lu, M.-K. Antrodia camphorata polysaccharides exhibit anti-hepatitis B virus effects. FEMS Microbiol. Lett. 2002, 209, 63–67. [Google Scholar] [CrossRef]
- Wu, M.-D.; Cheng, M.-J.; Wang, W.-Y.; Huang, H.-C.; Yuan, G.-F.; Chen, J.-J.; Chen, I.-S.; Wang, B.-C. Antioxidant activities of extracts and metabolites isolated from the fungus Antrodia cinnamomea. Nat. Prod. Res. 2011, 25, 1488–1496. [Google Scholar] [CrossRef]
- Cao, Y.-n.; Yue, S.-s.; Wang, A.-y.; Xu, L.; Hu, Y.-t.; Qiao, X.; Wu, T.-Y.; Ye, M.; Wu, Y.-C.; Qi, R. Antrodia cinnamomea and its compound dehydroeburicoic acid attenuate nonalcoholic fatty liver disease by upregulating ALDH2 activity. J. Ethnopharmacol. 2022, 292, 115146. [Google Scholar] [CrossRef]
- Chang, C.-C.; Lu, Y.-C.; Wang, C.-C.; Ko, T.-L.; Chen, J.-R.; Wang, W.; Chen, Y.-L.; Wang, Y.-W.; Chang, T.-H.; Hsu, H.-F. Antrodia cinnamomea extraction waste supplementation promotes thermal stress tolerance and tissue regeneration ability of zebrafish. Molecules 2020, 25, 4213. [Google Scholar] [CrossRef]
- Zhang, B.-B.; Guan, Y.-Y.; Hu, P.-F.; Chen, L.; Xu, G.-R.; Liu, L.; Cheung, P.C. Production of bioactive metabolites by submerged fermentation of the medicinal mushroom Antrodia cinnamomea: Recent advances and future development. Crit. Rev. Biotechnol. 2019, 39, 541–554. [Google Scholar] [CrossRef]
- Li, S.; Chen, G. Agricultural waste-derived superabsorbent hydrogels: Preparation, performance, and socioeconomic impacts. J. Clean. Prod. 2020, 251, 119669. [Google Scholar] [CrossRef]
- Ahmad, D.F.B.A.; Wasli, M.E.; Tan, C.S.Y.; Musa, Z.; Chin, S.-F. Eco-friendly cellulose-based hydrogels derived from wastepapers as a controlled-release fertilizer. Chem. Biol. Technol. Agric. 2023, 10, 36. [Google Scholar] [CrossRef]
- Cui, X.; Lee, J.J.; Chen, W.N. Eco-friendly and biodegradable cellulose hydrogels produced from low cost okara: Towards non-toxic flexible electronics. Sci. Rep. 2019, 9, 18166. [Google Scholar] [CrossRef]
- Jirawitchalert, S.; Mitaim, S.; Chen, C.-Y.; Patikarnmonthon, N. Cotton Cellulose-Derived Hydrogel and Electrospun Fiber as Alternative Material for Wound Dressing Application. Int. J. Biomater. 2022, 2022, 2502658. [Google Scholar] [CrossRef] [PubMed]
- Cui, X.; Lee, J.; Ng, K.R.; Chen, W.N. Food waste Durian rind-derived cellulose organohydrogels: Toward anti-freezing and antimicrobial wound dressing. ACS Sustain. Chem. Eng. 2021, 9, 1304–1312. [Google Scholar] [CrossRef]
- Zhang, X.; Sun, D.; Cai, J.; Liu, W.; Yan, N.; Qiu, X. Robust conductive hydrogel with antibacterial activity and UV-shielding performance. Ind. Eng. Chem. Res. 2020, 59, 17867–17875. [Google Scholar] [CrossRef]
- Sun, X.; Yao, M.; He, S.; Dong, X.; Liang, L.; Yao, F.; Li, J. Antibacterial and UV-Blocking Bioelectronics Based on Transparent, Adhesive, and Strain-Sensitive Multifunctional Hydrogel. Adv. Mater. Technol. 2022, 7, 2101283. [Google Scholar] [CrossRef]
- Zhang, M.; Yang, Q.; Hu, T.; Tang, L.; Ni, Y.; Chen, L.; Wu, H.; Huang, L.; Ding, C. Adhesive, antibacterial, conductive, anti-UV, self-healing, and tough collagen-based hydrogels from a pyrogallol-Ag self-catalysis system. ACS Appl. Mater. Interfaces 2022, 14, 8728–8742. [Google Scholar] [CrossRef]
- Cao, H.; Zhu, J.; Zhang, J.; Yang, L.; Guo, X.; Tian, R.; Wu, H.; Li, Y.; Gu, Z. In situ fabrication of robust polyphenolic hydrogels for skin protection and repair. Chem. Mater. 2023, 35, 2191–2201. [Google Scholar] [CrossRef]
- Xu, Z.; Yu, X.; Gao, F.; Zang, M.; Huang, L.; Liu, W.; Xu, J.; Yu, S.; Wang, T.; Sun, H. Fighting bacteria with bacteria: A biocompatible living hydrogel patch for combating bacterial infections and promoting wound healing. Acta Biomater. 2024, 181, 176–187. [Google Scholar] [CrossRef]
- Lv, H.; Liang, Q.; He, Y.; Liang, H.; Xiang, S.; Yuan, W.; Li, S.; Hong, J.; Wu, J.; Zhao, L. A transparent, moisturizing, antibacterial and mechanically flexible hydrogel for emergency conservation of unearthed bone relics. Eur. Polym. J. 2025, 222, 113590. [Google Scholar] [CrossRef]
- Asadi, N.; Pazoki-Toroudi, H.; Del Bakhshayesh, A.R.; Akbarzadeh, A.; Davaran, S.; Annabi, N. Multifunctional hydrogels for wound healing: Special focus on biomacromolecular based hydrogels. Int. J. Biol. Macromol. 2021, 170, 728–750. [Google Scholar] [CrossRef] [PubMed]
- Ding, Y.-W.; Zhang, Z.-W.; Cui, X.-Y.; Hu, R.-Y.; Li, Y.; Huang, S.-D.; Du, S.-Q.; Dao, J.-W.; Wei, D.-X. ZnCur nanoparticle-enhanced multifunctional hydrogel platform: Synergistic antibacterial and immunoregulatory effects for infected diabetic wound healing. Chem. Eng. J. 2025, 503, 158387. [Google Scholar] [CrossRef]
- Cadet, J.; Douki, T.; Ravanat, J.L. Oxidatively generated damage to cellular DNA by UVB and UVA radiation. Photochem. Photobiol. 2015, 91, 140–155. [Google Scholar] [CrossRef]
- Pourzand, C.; Tyrrell, R.M. INVITED REVIEW-Apoptosis, the role of oxidative stress and the example of solar UV radiation. Photochem. Photobiol. 1999, 70, 380–390. [Google Scholar] [CrossRef]
- Irede, E.L.; Awoyemi, R.F.; Owolabi, B.; Aworinde, O.R.; Kajola, R.O.; Hazeez, A.; Raji, A.A.; Ganiyu, L.O.; Onukwuli, C.O.; Onivefu, A.P. Cutting-edge developments in zinc oxide nanoparticles: Synthesis and applications for enhanced antimicrobial and UV protection in healthcare solutions. RSC Adv. 2024, 14, 20992–21034. [Google Scholar] [CrossRef]
- Ni, Z.; Yu, H.; Wang, L.; Huang, Y.; Lu, H.; Zhou, H.; Liu, Q. Multistage ROS-responsive and natural polyphenol-driven prodrug hydrogels for diabetic wound healing. ACS Appl. Mater. Interfaces 2022, 14, 52643–52658. [Google Scholar] [CrossRef]
- Cavallini, C.; Vitiello, G.; Adinolfi, B.; Silvestri, B.; Armanetti, P.; Manini, P.; Pezzella, A.; d’Ischia, M.; Luciani, G.; Menichetti, L. Melanin and melanin-like hybrid materials in regenerative medicine. Nanomaterials 2020, 10, 1518. [Google Scholar] [CrossRef] [PubMed]
- Zivari-Ghader, T.; Rashidi, M.-R.; Mehrali, M. Biological macromolecule-based hydrogels with antibacterial and antioxidant activities for wound dressing: A review. Int. J. Biol. Macromol. 2024, 279, 134578. [Google Scholar] [CrossRef]
- Birch-Machin, M.; Russell, E.; Latimer, J. Mitochondrial DNA damage as a biomarker for ultraviolet radiation exposure and oxidative stress. Br. J. Dermatol. 2013, 169, 9–14. [Google Scholar] [CrossRef]
- Ge, X.; Hu, J.; Qi, X.; Shi, Y.; Chen, X.; Xiang, Y.; Xu, H.; Li, Y.; Zhang, Y.; Shen, J. An Immunomodulatory Hydrogel Featuring Antibacterial and Reactive Oxygen Species Scavenging Properties for Treating Periodontitis in Diabetes. Adv. Mater. 2025, 37, 2412240. [Google Scholar] [CrossRef]
- Yang, J.; Shen, L.; Zhao, Y.; Zhou, X.; Liu, Y. Antioxidant and antibacterial coconut mesocarp polyphenol hydrogel dressing based on PVA/quaternary chitosan/sodium alginate with β-glycerophosphate. Int. J. Biol. Macromol. 2025, 291, 138923. [Google Scholar] [CrossRef] [PubMed]
- Aldakheel, F.M.; Wickramasinghe, R.; Thamaraiselvan, C.; Sayed, M.M.E.; Fagir, M.H.; Dein, D.K.E.; Mohsen, D. Green silver nanoparticle-embedded chitosan-alginate hydrogel: A novel antibacterial approach for potential wound healing. Polym. Polym. Compos. 2025, 33, 09673911251320463. [Google Scholar] [CrossRef]
- Heydari, N.; Karimi, A.R.; Momeni, H.R.; Azadikhah, F.; Etemadi, T. Chitosan Schiff-Base Hydrogel Sunscreen: A Multifunctional Hybrid Network with Antioxidant, Ultraviolet-Shielding, and Self-Healing Properties. ACS Omega 2025, 10, 8250–8261. [Google Scholar] [CrossRef] [PubMed]
- Liu, Y.; Qin, D.; Wang, H.; Zhu, Y.; Bi, S.; Liu, Y.; Cheng, X.; Chen, X. Effect and mechanism of fish scale extract natural hydrogel on skin protection and cell damage repair after UV irradiation. Colloids Surf. B Biointerfaces 2023, 225, 113281. [Google Scholar] [CrossRef]
- Nath, P.C.; Debnath, S.; Sharma, M.; Sridhar, K.; Nayak, P.K.; Inbaraj, B.S. Recent advances in cellulose-based hydrogels: Food applications. Foods 2023, 12, 350. [Google Scholar] [CrossRef]
- Gyles, D.A.; Castro, L.D.; Silva, J.O.C., Jr.; Ribeiro-Costa, R.M. A review of the designs and prominent biomedical advances of natural and synthetic hydrogel formulations. Eur. Polym. J. 2017, 88, 373–392. [Google Scholar] [CrossRef]
- Li, S.; Miao, Y.-A.; Zhang, M.; Reheman, A.; Huang, L.-L.; Chen, L.-H.; Wu, H. Anti-UV antibacterial conductive lignin-copolymerized hydrogel for pressure sensing. J. For. Eng. 2022, 6, 114–123. [Google Scholar]
- Tang, Z.; Yu, M.; Yang, Y.; Pan, Y.; Mondal, A.K.; Lin, X. Development of an antioxidant and UV-shielding composite hydrogel using mussel-inspired cellulose nanocrystals, polydopamine, and poly (vinyl alcohol) for application in sunscreens. ACS Appl. Polym. Mater. 2023, 5, 6625–6632. [Google Scholar] [CrossRef]
- Yang, Y.; Xu, H.; Li, M.; Li, Z.; Zhang, H.; Guo, B.; Zhang, J. Antibacterial conductive UV-blocking adhesion hydrogel dressing with mild on-demand removability accelerated drug-resistant bacteria-infected wound healing. ACS Appl. Mater. Interfaces 2022, 14, 41726–41741. [Google Scholar] [CrossRef]
- Liu, Y.; Huang, J.; Xu, Z.; Li, S.; Jiang, Y.; wen Qu, G.; Li, Z.; Zhao, Y.; Wu, X.; Ren, J. Fabrication of gelatin-based printable inks with improved stiffness as well as antibacterial and UV-shielding properties. Int. J. Biol. Macromol. 2021, 186, 396–404. [Google Scholar] [CrossRef]
- Choi, H.-k.; Kim, D.-h.; Kim, J.W.; Ngadiran, S.; Sarmidi, M.R.; Park, C.S. Labisia pumila extract protects skin cells from photoaging caused by UVB irradiation. J. Biosci. Bioeng. 2010, 109, 291–296. [Google Scholar] [CrossRef]
- Ullah, S.; Khalil, A.A.; Shaukat, F.; Song, Y. Sources, extraction and biomedical properties of polysaccharides. Foods 2019, 8, 304. [Google Scholar] [CrossRef]
- You, Q.; Yin, X.; Zhang, S.; Jiang, Z. Extraction, purification, and antioxidant activities of polysaccharides from Tricholoma mongolicum Imai. Carbohydr. Polym. 2014, 99, 1–10. [Google Scholar] [CrossRef] [PubMed]
- Cullen, L.E.; MacFarlane, C. Comparison of cellulose extraction methods for analysis of stable isotope ratios of carbon and oxygen in plant material. Tree Physiol. 2005, 25, 563–569. [Google Scholar] [CrossRef] [PubMed]
- Astashkina, A.; Mann, B.; Grainger, D.W. A critical evaluation of in vitro cell culture models for high-throughput drug screening and toxicity. Pharmacol. Ther. 2012, 134, 82–106. [Google Scholar] [CrossRef]
- Cai, L.; Qin, X.; Xu, Z.; Song, Y.; Jiang, H.; Wu, Y.; Ruan, H.; Chen, J. Comparison of cytotoxicity evaluation of anticancer drugs between real-time cell analysis and CCK-8 method. ACS Omega 2019, 4, 12036–12042. [Google Scholar] [CrossRef]
- Wang, N.; Li, X.; Yang, Y.; Shang, Y.; Zhuang, X.; Li, H.; Zhou, Z. Combined process of visible light irradiation photocatalysis-coagulation enhances natural organic matter removal: Optimization of influencing factors and mechanism. Chem. Eng. J. 2019, 374, 748–759. [Google Scholar] [CrossRef]
- Kawashima, S.; Funakoshi, T.; Sato, Y.; Saito, N.; Ohsawa, H.; Kurita, K.; Nagata, K.; Yoshida, M.; Ishigami, A. Protective effect of pre-and post-vitamin C treatments on UVB-irradiation-induced skin damage. Sci. Rep. 2018, 8, 16199. [Google Scholar] [CrossRef] [PubMed]
- Jiao, G.; He, X.; Li, X.; Qiu, J.; Xu, H.; Zhang, N.; Liu, S. Limitations of MTT and CCK-8 assay for evaluation of graphene cytotoxicity. Rsc Adv. 2015, 5, 53240–53244. [Google Scholar] [CrossRef]
- Taylor, S.C.; Posch, A. The design of a quantitative western blot experiment. BioMed Res. Int. 2014, 2014, 361590. [Google Scholar] [CrossRef]
- Xu, C.; Yang, X.; Wang, X.; Jing, L.; Zhou, Z.; Cao, Y.; Zheng, H.; Kuo, C.-L.; Huang, D. Authentication of ten distinctive triterpenoids in Antrodia cinnamomea serves as a crucial aspect for ensuring the quality control of associated nutraceutical products. Curr. Res. Food Sci. 2024, 8, 100721. [Google Scholar] [CrossRef] [PubMed]
- Steppuhn, A.; Wäckers, F. HPLC sugar analysis reveals the nutritional state and the feeding history of parasitoids. Funct. Ecol. 2004, 18, 812–819. [Google Scholar] [CrossRef]
- Cai, J.; Liu, Y.; Zhang, L. Dilute solution properties of cellulose in LiOH/urea aqueous system. J. Polym. Sci. Part B Polym. Phys. 2006, 44, 3093–3101. [Google Scholar] [CrossRef]
- Wang, S.; Zhang, R.; Yang, Y.; Wu, S.; Cao, Y.; Lu, A.; Zhang, L. Strength enhanced hydrogels constructed from agarose in alkali/urea aqueous solution and their application. Chem. Eng. J. 2018, 331, 177–184. [Google Scholar] [CrossRef]
- Meyvis, T.; De Smedt, S.; Demeester, J.; Hennink, W. Influence of the degradation mechanism of hydrogels on their elastic and swelling properties during degradation. Macromolecules 2000, 33, 4717–4725. [Google Scholar] [CrossRef]
- Beaumont, M.; Tran, R.; Vera, G.; Niedrist, D.; Rousset, A.; Pierre, R.; Shastri, V.P.; Forget, A. Hydrogel-forming algae polysaccharides: From seaweed to biomedical applications. Biomacromolecules 2021, 22, 1027–1052. [Google Scholar] [CrossRef]
- Drury, J.L.; Dennis, R.G.; Mooney, D.J. The tensile properties of alginate hydrogels. Biomaterials 2004, 25, 3187–3199. [Google Scholar] [CrossRef] [PubMed]
- Capella, V.; Rivero, R.E.; Liaudat, A.C.; Ibarra, L.E.; Roma, D.A.; Alustiza, F.; Manas, F.; Barbero, C.A.; Bosch, P.; Rivarola, C.R. Cytotoxicity and bioadhesive properties of poly-N-isopropylacrylamide hydrogel. Heliyon 2019, 5, e01474. [Google Scholar] [CrossRef] [PubMed]
- Morris, C.P.; Bergman, Y.; Tekle, T.; Fissel, J.A.; Tamma, P.D.; Simner, P.J. Cefiderocol antimicrobial susceptibility testing against multidrug-resistant Gram-negative bacilli: A comparison of disk diffusion to broth microdilution. J. Clin. Microbiol. 2020, 59. [Google Scholar] [CrossRef]
- Gupta, A.; Low, W.L.; Radecka, I.; Britland, S.T.; Mohd Amin, M.C.I.; Martin, C. Characterisation and in vitro antimicrobial activity of biosynthetic silver-loaded bacterial cellulose hydrogels. J. Microencapsul. 2016, 33, 725–734. [Google Scholar] [CrossRef]

| GROUP NAME | ECH Concentration | CH2O/wt% |
|---|---|---|
| ND | 6% | ND |
| ND | 7% | ND |
| I | 8% | 89 ± 2 |
| II | 9% | 91 ± 1 |
| III | 10% | 91 ± 1 |
| IV | 11% | 92 ± 1 |
| V | 12% | 93 ± 2 |
| VI | 8% | 89 ± 1 |
Disclaimer/Publisher’s Note: The statements, opinions and data contained in all publications are solely those of the individual author(s) and contributor(s) and not of MDPI and/or the editor(s). MDPI and/or the editor(s) disclaim responsibility for any injury to people or property resulting from any ideas, methods, instructions or products referred to in the content. |
© 2025 by the authors. Licensee MDPI, Basel, Switzerland. This article is an open access article distributed under the terms and conditions of the Creative Commons Attribution (CC BY) license (https://creativecommons.org/licenses/by/4.0/).
Share and Cite
Xu, C.; Chen, S.; Liu, T.; Zhu, H.; Kuo, C.-L.; Zhou, Z.; Chen, G.; Chin, F.W.L.; Yang, X.; Huang, D. Antrodia cinnamomea Residual Biomass-Based Hydrogel as a Novel UV-Protective and Antimicrobial Wound-Healing Dressing for Biomedical Use. Int. J. Mol. Sci. 2025, 26, 4496. https://doi.org/10.3390/ijms26104496
Xu C, Chen S, Liu T, Zhu H, Kuo C-L, Zhou Z, Chen G, Chin FWL, Yang X, Huang D. Antrodia cinnamomea Residual Biomass-Based Hydrogel as a Novel UV-Protective and Antimicrobial Wound-Healing Dressing for Biomedical Use. International Journal of Molecular Sciences. 2025; 26(10):4496. https://doi.org/10.3390/ijms26104496
Chicago/Turabian StyleXu, Chunyuhang, Siyu Chen, Tiange Liu, Haowen Zhu, Chien-Liang Kuo, Zhuoyu Zhou, Guo Chen, Fion Wei Lin Chin, Xin Yang, and Dejian Huang. 2025. "Antrodia cinnamomea Residual Biomass-Based Hydrogel as a Novel UV-Protective and Antimicrobial Wound-Healing Dressing for Biomedical Use" International Journal of Molecular Sciences 26, no. 10: 4496. https://doi.org/10.3390/ijms26104496
APA StyleXu, C., Chen, S., Liu, T., Zhu, H., Kuo, C.-L., Zhou, Z., Chen, G., Chin, F. W. L., Yang, X., & Huang, D. (2025). Antrodia cinnamomea Residual Biomass-Based Hydrogel as a Novel UV-Protective and Antimicrobial Wound-Healing Dressing for Biomedical Use. International Journal of Molecular Sciences, 26(10), 4496. https://doi.org/10.3390/ijms26104496











